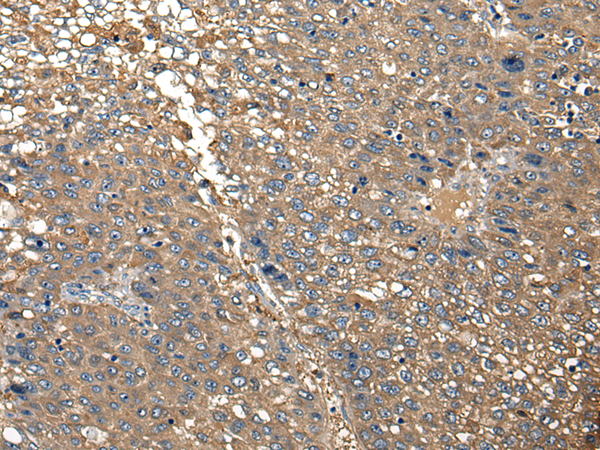
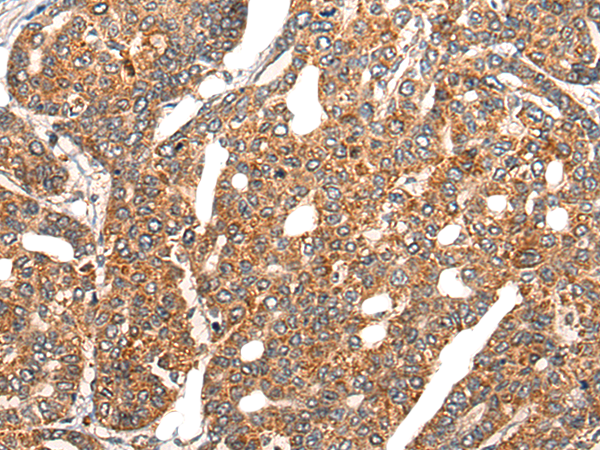
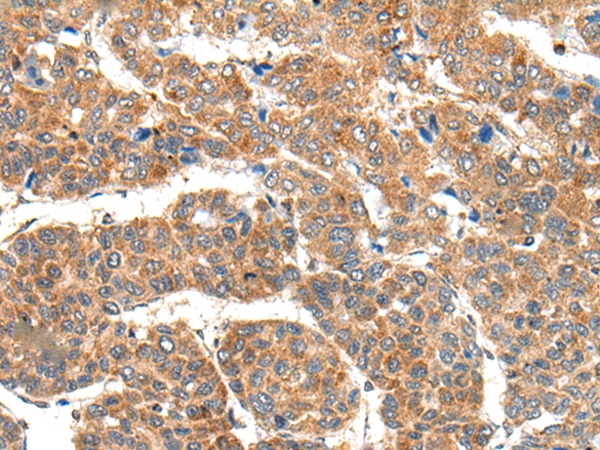

-
分类: 科研抗体货号: P13137别名: RNF116; RNF196应用: WB,IHC反应种属: Human
-
分类: 科研抗体货号: P13136别名: DGK-IOTA应用: IHC反应种属: Human
-
分类: 科研抗体货号: P13135别名: EHK2; EK12; EPA6; EHK-2; HEK12; PRO57066应用: WB,IHC反应种属: Human, Mouse, Rat
-
分类: 科研抗体货号: P13154别名: C3orf41; FAM198A应用: IHC反应种属: Human, Mouse
-
分类: 科研抗体货号: P13134别名: PKY; YAK1; DYRK6; FIST3应用: IHC反应种属: Human, Rat
-
分类: 科研抗体货号: P13153别名: NARF; HSD-4; STRIN; hNARF应用: IHC反应种属: Human, Mouse, Rat
-
分类: 科研抗体货号: P13132别名: EBP50; NHERF; NHERF1; NHERF-1; NPHLOP2应用: IHC反应种属: Human, Mouse, Rat
-
分类: 科研抗体货号: P13152别名: LC3B; ATG8F; MAP1LC3B-a; MAP1A/1BLC3应用: WB,IHC反应种属: Human, Mouse, Rat
-
分类: 科研抗体货号: P13130别名: CSS1; OSA2; 6A3-5; DAN15; MRD12; P250R; BRIGHT; BAF250B; ELD/OSA1应用: IHC反应种属: Human
-
分类: 科研抗体货号: P13150别名: L14; RL14; hRL14; CTG-B33; CAG-ISL-7应用: WB,IHC反应种属: Human, Mouse, Rat

鄂公网安备42018502007531号
鄂公网安备42018502007531号

